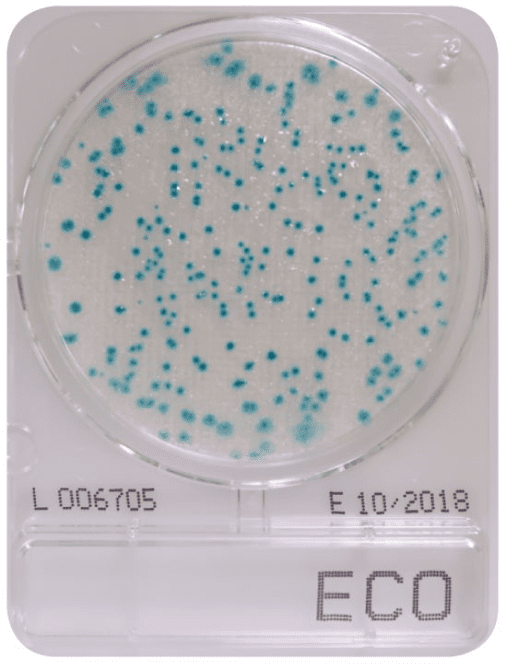

CompactDry ECO is a ready-to-use plate enabling easy culture and enumeration of E. coli in solid food stuff (homogenized with buffer solution), water/liquid samples and swab based environmental testing for surfaces and production areas.
E. coli form blue colonies due to the chromogenic enzyme substrate, X-Gluc contained in the dehydrated selective media.
Precaution for interpretation:
E. coli O157 does not produce beta glucuronidase. So, E. coli O157 colonies on CompactDry ECO are not coloured and form white colonies.